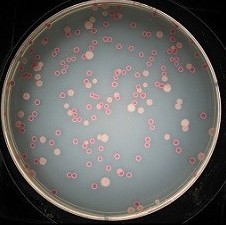
��������������ģǹ���¼�

RENEE MONTAGNE, HOST: Every day, researchers in a Michigan lab carefully tend to a dozen glass bottles full of bacteria. That bacteria started out as identical but the separate populations have been evolving for 25 years. This unique long-term experiment is letting scientists watch evolution happen in real time.
NPR's Nell Greenfieldboyce reports on their latest and surprising discovery.
(SOUNDBITE OF MACHINERY)
NELL GREENFIELDBOYCE, BYLINE: When I visited Richard Lenski's lab at Michigan State University about a year ago, he opened up an incubator to introduce me to some old friends.
RICHARD LENSKI: These 12 flasks here are the 12 populations of this long-term experiment that's been going on in the lab since 1988.
GREENFIELDBOYCE: The E. coli bacteria in these flasks just eat and divide, eat and divide. In the last quarter-century, they've produced over 50,000 generations and random mutations have allowed them to get fitter.
LENSKI: In evolutionary biology, fitness is this representation of the ability of an organism to survive and reproduce.
GREENFIELDBOYCE: For his bacteria, being fitter means reproducing faster. Because all things being equal...
LENSKI: Organisms that reproduce more quickly will have an advantage in competition with those that reproduce more slowly.
GREENFIELDBOYCE: Now, biologists have long thought that evolution goes on and on and never stops because the world is constantly changing - maybe the climate heats up, maybe an asteroid hits, and life has to adapt. But Lenski's bacteria live in an unchanging world. Their glass bottles stay at a steady temperature. They constantly are fed the same food. So early on, Lenski predicted his bacteria would adapt and adapt but eventually hit a wall - a peak level of fitness they couldn't improve on.
It turns out, that's not how it is. Lenski and his team have just published a report in the journal Science. It shows the bacteria have not stopped evolving and it looks like they never will. Lenski's group did their new analysis with the help of something he showed me at his lab, a freezer.
LENSKI: In here we have racks of little boxes. And in the little boxes are little glass vials.
GREENFIELDBOYCE: And in the little glass vials are samples of the bacteria that were taken every few months over the whole course of this experiment. Lenski can pull out, say, the thousandth generation, or the 40,000th generation, and bring these frozen bacteria back to life.
LENSKI: We can actually compete organisms that lived at different points in time. So we can compete the evolved bacteria head-to-head against their ancestors.
GREENFIELDBOYCE: To measure how fit they are. What the scientists found is that the bacteria have just been getting fitter and fitter and fitter. The pace of improvement is slowing down but shows no sign of stopping. In their tests, the original ancestor can double its population in about an hour. Fifty-thousand generation later, the bacteria do that in 40 minutes. Lenski calculates that future generations will reproduce even faster.
LENSKI: We predicted that in about a million years, their doubling time might be on the order of about 20 minutes.
GREENFIELDBOYCE: That would be a lot of change for creatures living in an unchanging world. And it offers a new perspective on just how relentless evolution really is. I asked Lenski if he thought his long-term experiment would still be around in million years, to test his predictions.
LENSKI: I doubt it. But I would love to see it continue for at least another 25 years. I think it's still got a lot to teach us about how evolution works under these very idealized, but very transparent conditions.
GREENFIELDBOYCE: Eventually, Lenski plans to hand the experiment off to another, younger scientist.
Nell Greenfieldboyce, NPR News.

